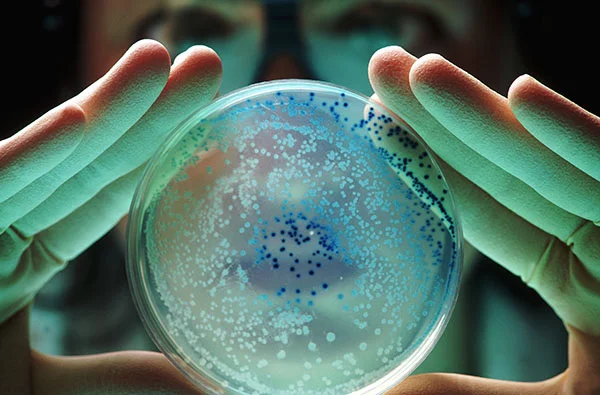

La exploración espacial ha dado un nuevo giro con el descubrimiento de una bacteria inédita en la estación espacial china Tiangong. Este hallazgo, que ha activado una alerta máxima, plantea interrogantes sobre la adaptabilidad de la vida en condiciones extremas y sus implicaciones tanto para misiones espaciales como para la ciencia terrestre.
Un microbio adaptado al espacio
Denominada Niallia tiangongensis, esta bacteria fue encontrada en una cabina de la estación Tiangong. Aunque es una variante de un microbio terrestre conocido, ha desarrollado características únicas que le permiten sobrevivir en condiciones extremas como la radiación y la microgravedad. Este descubrimiento fue realizado por el Grupo de Biotecnología Espacial Shenzhou y el Instituto de Ingeniería de Sistemas Espaciales de Beijing, y publicado en la revista International Journal of Systematic and Evolutionary Microbiology.
El microbio no solo sobrevive, sino que repara daños y maneja el estrés oxidativo causado por la radiación espacial. Estas adaptaciones lo convierten en un modelo ideal para estudiar la resistencia biológica en entornos hostiles, lo que podría tener aplicaciones significativas en la protección de astronautas y sistemas espaciales.
Importancia de los microbios en el espacio
Los microbios son un componente crucial en ambientes cerrados como las estaciones espaciales. Si bien pueden representar riesgos para la salud de los astronautas y los sistemas de la nave, también ofrecen oportunidades para la innovación científica. Por ejemplo, el estudio de Niallia tiangongensis podría conducir al desarrollo de nuevos antibióticos, terapias contra la radiación y biomateriales duraderos.
Además, este hallazgo resalta la importancia de comprender cómo los microbios responden a las condiciones espaciales. Estos conocimientos son esenciales para garantizar la seguridad en misiones prolongadas y para explorar la posibilidad de establecer hábitats sostenibles en otros planetas.
Implicaciones para el futuro de la exploración espacial
El descubrimiento de Niallia tiangongensis abre nuevas posibilidades para la investigación científica y tecnológica. La capacidad de este microbio para adaptarse y prosperar en el espacio podría inspirar soluciones innovadoras para desafíos tanto en la Tierra como en futuras misiones a Marte y más allá.
La Agencia Espacial Tripulada de China ha descrito este hallazgo como parte de una «cosecha de descubrimientos excepcionales» que conectan la genética y el metabolismo microbiano con aplicaciones prácticas. Este avance subraya cómo la exploración espacial no solo se trata de cohetes y estrellas, sino también de entender la vida misma.
Continúa tu carrera profesional
Si te apasiona la biotecnología y la exploración espacial, la Maestría en Proyectos de Innovación y Producto de FUNIBER puede proporcionarte las herramientas necesarias para liderar proyectos innovadores en estos campos en constante evolución.
Fuentes:
Times Now News
Elcabildo
